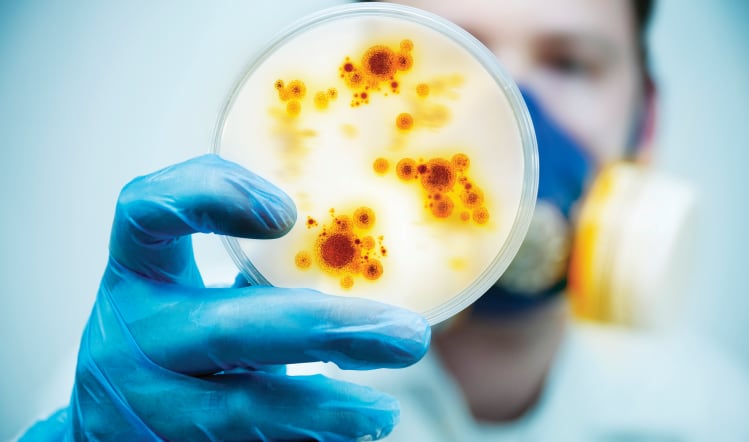

Court Order backs phage use against listeria
Food firms can keep using phages to fight listeria on ready-to-eat foods in the absence of a developed EU legal framework, according to a European Court of Justice Court Order.

Food firms can keep using phages to fight listeria on ready-to-eat foods in the absence of a developed EU legal framework, according to a European Court of Justice Court Order.

Tulip Ltd’s planned 270 job cuts as it faces the closure of its Bodmin plant in Cornwall represent ‘another shock wave to the already battered Cornish economy’, according to trade union Unite.

Drinks manufacturer Nichols has appointed David Rattigan as its new chief financial officer (CFO), effective from 24 February next year.
Newcastle-based software firm Luminous Group has secured £400,000 in funding to develop new artificial intelligence (AI) to vastly reduce pathogens in food processing plants, with one major manufacturer already claiming increased efficiencies as a result.